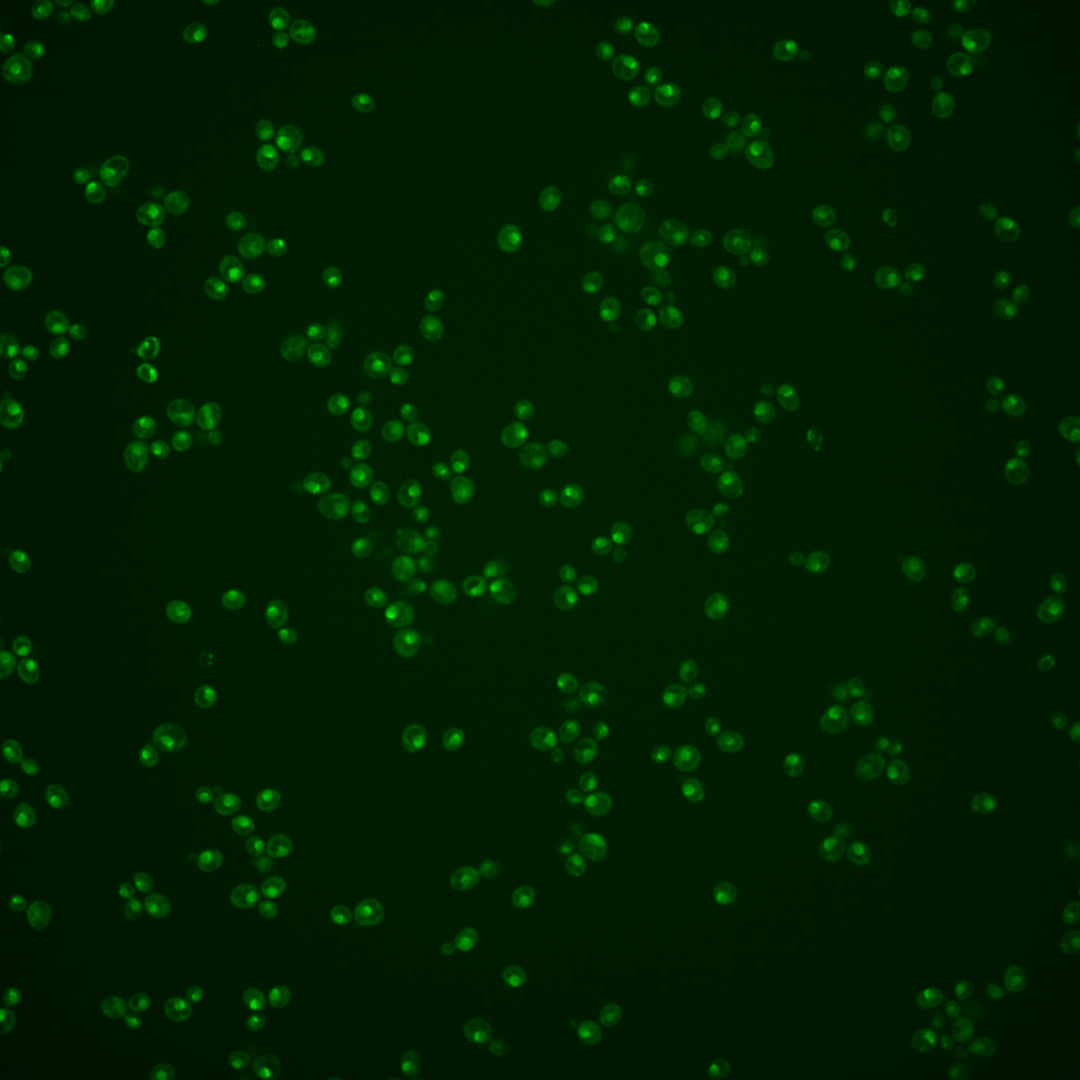
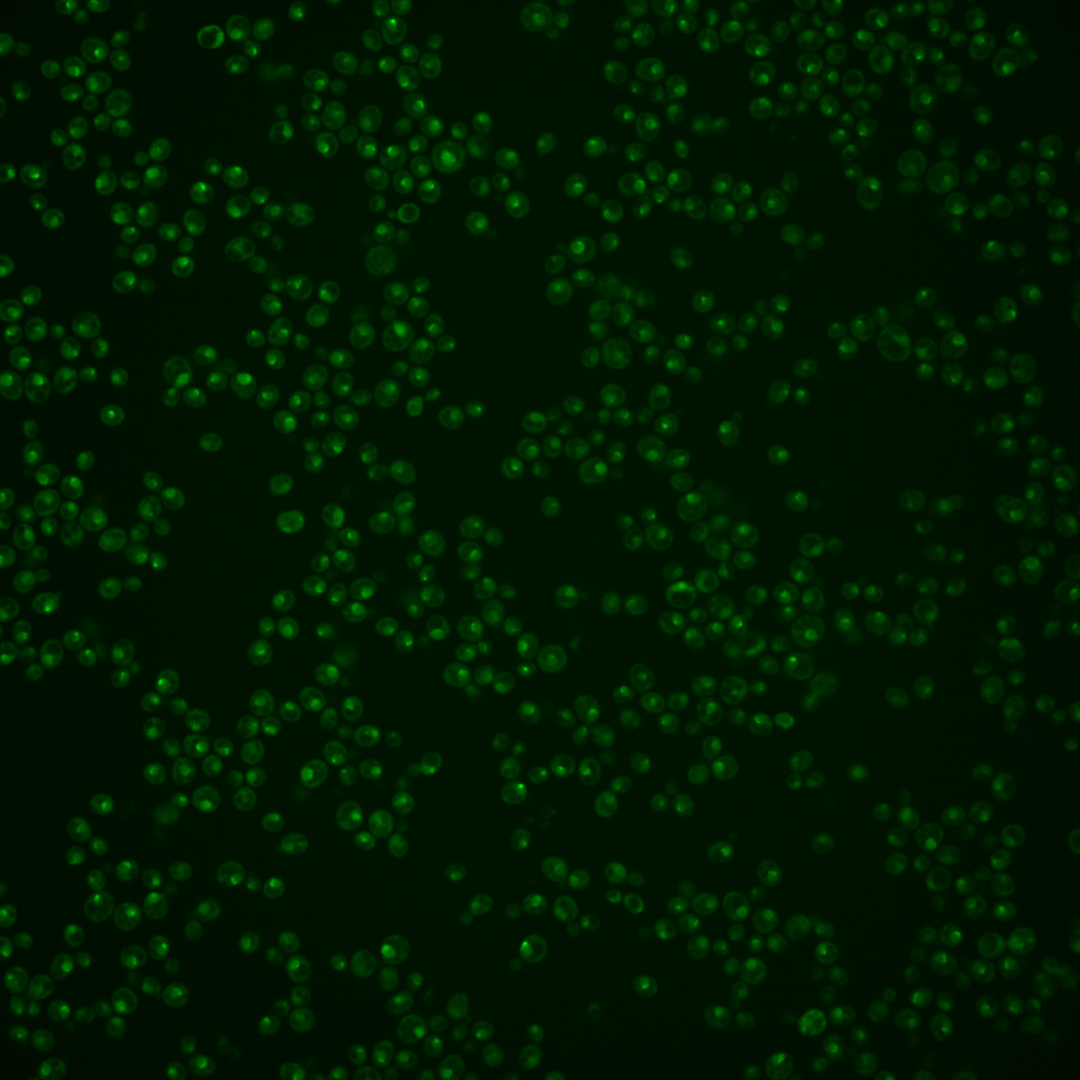
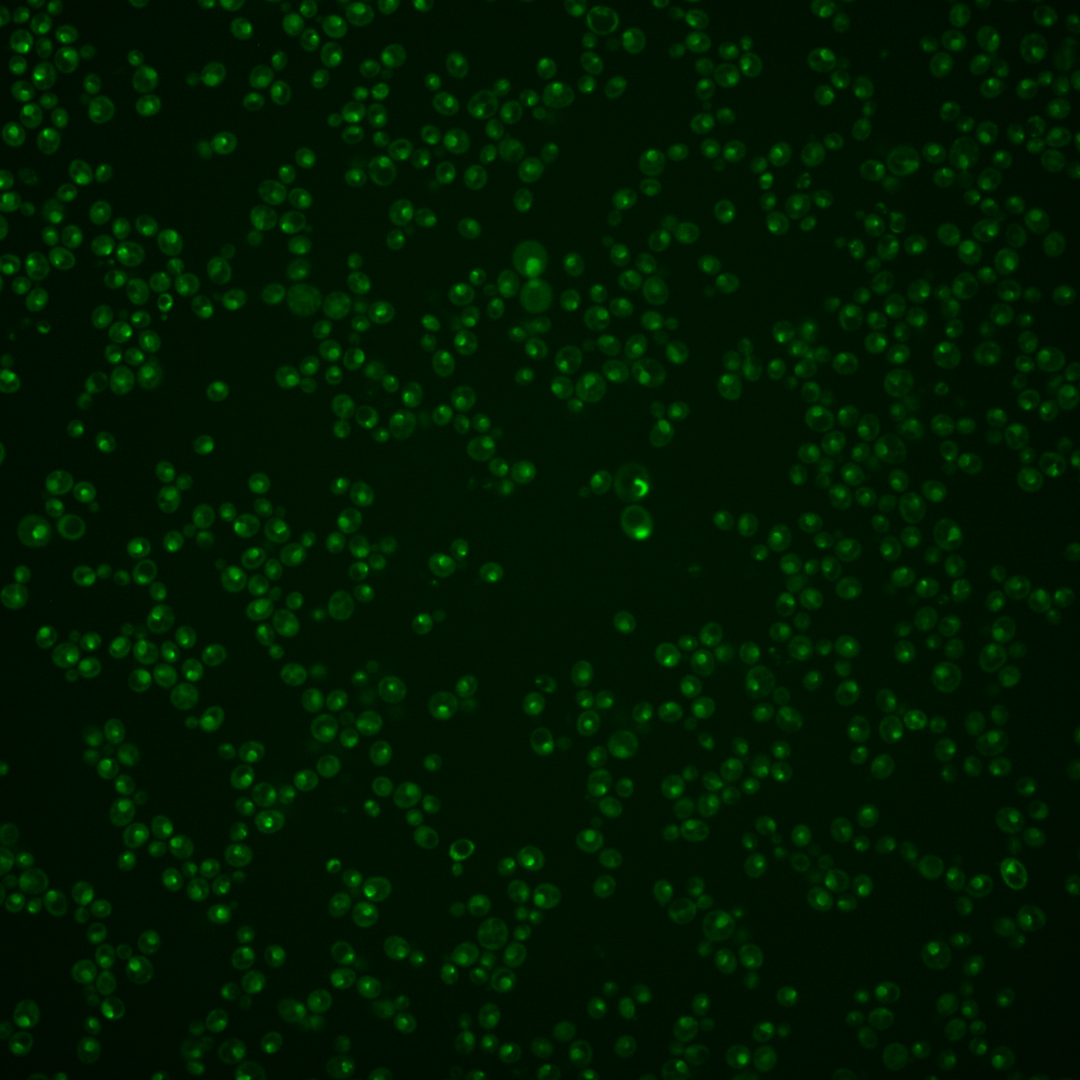

| Standard name | |
|---|---|
| Human Ortholog | |
| Description | Nucleolar S-adenosylmethionine-dependent rRNA methyltransferase; methylates adenine (m1A) of the large subunit (LSU) rRNA at position 2142; belongs to Rossmann fold superfamily; green fluorescent protein (GFP)-fusion protein localizes to the nucleolus; YBR141C is not an essential gene |
Micrographs




















































































Sub-cellular Localization
Yeast GFP Assignment
Protein Abundance
Localization Change
External localization resources
| ensLOC | DeepLoc | |||||||||||||||||||||||
|---|---|---|---|---|---|---|---|---|---|---|---|---|---|---|---|---|---|---|---|---|---|---|---|---|
| Localization | WT1 | WT2 | WT3 | RAP60 | RAP140 | RAP220 | RAP300 | RAP380 | RAP460 | RAP540 | RAP620 | RAP700 | HU80 | HU120 | HU160 | rpd3Δ_1 | rpd3Δ_2 | rpd3Δ_3 | WT1 | WT2 | WT3 | AF100 | AF140 | AF180 |
| Cortical Patches | 0 | 0 | 0 | 0 | 1 | 0 | 0 | 1 | 0 | 0 | 0 | 0 | 0 | 0 | 0 | 1 | 0 | 0 | 0 | 0 | 0 | 0 | 1 | 2 |
| Bud | 0 | 0 | 1 | 3 | 3 | 7 | 15 | 13 | 14 | 17 | 15 | 18 | 2 | 1 | 1 | 3 | 0 | 0 | 3 | 1 | 1 | 2 | 7 | 11 |
| Bud Neck | 0 | 0 | 0 | 16 | 9 | 12 | 8 | 15 | 8 | 15 | 7 | 15 | 6 | 22 | 9 | 0 | 0 | 0 | 0 | 1 | 2 | 3 | 12 | 12 |
| Bud Site | 1 | 0 | 1 | 2 | 7 | 13 | 14 | 13 | 19 | 23 | 14 | 14 | 2 | 2 | 0 | 0 | 0 | 2 | – | – | – | – | – | – |
| Cell Periphery | 0 | 0 | 0 | 0 | 0 | 0 | 0 | 0 | 0 | 0 | 0 | 0 | 0 | 1 | 0 | 1 | 0 | 1 | 0 | 0 | 0 | 0 | 0 | 0 |
| Cytoplasm | 7 | 8 | 8 | 13 | 40 | 41 | 56 | 65 | 53 | 63 | 52 | 48 | 29 | 90 | 116 | 17 | 5 | 12 | 1 | 2 | 1 | 1 | 10 | 18 |
| Endoplasmic Reticulum | 1 | 0 | 0 | 0 | 0 | 0 | 0 | 1 | 0 | 0 | 0 | 0 | 0 | 0 | 1 | 7 | 3 | 3 | 0 | 0 | 0 | 0 | 2 | 2 |
| Endosome | 0 | 2 | 1 | 6 | 14 | 14 | 4 | 4 | 3 | 1 | 1 | 1 | 9 | 60 | 117 | 12 | 6 | 9 | 16 | 11 | 4 | 35 | 87 | 103 |
| Golgi | 0 | 0 | 0 | 0 | 0 | 0 | 0 | 0 | 0 | 0 | 0 | 0 | 0 | 2 | 1 | 2 | 2 | 5 | 1 | 1 | 0 | 1 | 1 | 4 |
| Mitochondria | 183 | 15 | 13 | 11 | 21 | 89 | 140 | 73 | 198 | 155 | 227 | 136 | 17 | 10 | 12 | 18 | 8 | 28 | 7 | 0 | 4 | 7 | 27 | 21 |
| Nucleus | 228 | 109 | 107 | 28 | 63 | 34 | 28 | 19 | 28 | 38 | 33 | 23 | 117 | 245 | 151 | 79 | 52 | 51 | 125 | 78 | 55 | 48 | 49 | 31 |
| Nuclear Periphery | 11 | 3 | 1 | 0 | 0 | 0 | 0 | 0 | 0 | 0 | 0 | 0 | 0 | 1 | 0 | 1 | 0 | 0 | 23 | 2 | 5 | 0 | 8 | 8 |
| Nucleolus | 78 | 35 | 10 | 88 | 22 | 28 | 16 | 13 | 16 | 19 | 15 | 8 | 125 | 298 | 121 | 76 | 59 | 93 | 157 | 72 | 54 | 123 | 159 | 155 |
| Peroxisomes | 0 | 0 | 0 | 0 | 1 | 1 | 2 | 0 | 1 | 0 | 0 | 1 | 0 | 2 | 7 | 0 | 1 | 0 | 0 | 0 | 0 | 0 | 2 | 1 |
| SpindlePole | 7 | 2 | 22 | 122 | 76 | 85 | 83 | 80 | 65 | 75 | 48 | 74 | 133 | 382 | 267 | 39 | 8 | 17 | 23 | 6 | 15 | 73 | 120 | 129 |
| Vac/Vac Membrane | 19 | 8 | 3 | 1 | 10 | 6 | 3 | 3 | 4 | 4 | 8 | 6 | 2 | 4 | 13 | 11 | 6 | 12 | 29 | 18 | 13 | 20 | 40 | 52 |
| Unique Cell Count | 373 | 160 | 139 | 177 | 203 | 231 | 259 | 227 | 281 | 283 | 292 | 254 | 300 | 742 | 564 | 195 | 118 | 172 | 394 | 198 | 161 | 326 | 547 | 581 |
| Labelled Cell Count | 535 | 182 | 167 | 290 | 267 | 330 | 369 | 300 | 409 | 410 | 420 | 344 | 442 | 1120 | 816 | 267 | 150 | 233 | 394 | 198 | 161 | 326 | 547 | 581 |
Yeast GFP Assignment
Protein Abundance
| Screen | WT1 | WT2 | WT3 | RAP60 | RAP140 | RAP220 | RAP300 | RAP380 | RAP460 | RAP540 | RAP620 | RAP700 | HU80 | HU120 | HU160 | rpd3Δ_1 | rpd3Δ_2 | rpd3Δ_3 | AF100 | AF140 | AF180 |
|---|---|---|---|---|---|---|---|---|---|---|---|---|---|---|---|---|---|---|---|---|---|
| Mean Cell GFP Intensity (1e-4) | 4.3 | 5.9 | 5.2 | 5.3 | 5.5 | 4.3 | 3.8 | 4.4 | 3.2 | 3.5 | 3.1 | 3.5 | 5.5 | 5.6 | 5.5 | 8.2 | 7.7 | 7.3 | 5.9 | 5.6 | 6.1 |
| Std Deviation (1e-4) | 0.6 | 1.2 | 0.8 | 1.7 | 2.6 | 2.3 | 2.0 | 2.0 | 0.9 | 1.0 | 0.9 | 0.7 | 1.1 | 1.0 | 1.9 | 1.7 | 1.7 | 1.9 | 1.5 | 1.9 | 2.0 |
| Intensity Change (Log2) | – | – | – | 0.02 | 0.07 | -0.28 | -0.44 | -0.24 | -0.7 | -0.55 | -0.75 | -0.58 | 0.08 | 0.11 | 0.08 | 0.66 | 0.57 | 0.5 | 0.18 | 0.12 | 0.23 |
Localization Change
| Localization | RAP60 | RAP140 | RAP220 | RAP300 | RAP380 | RAP460 | RAP540 | RAP620 | RAP700 | HU80 | HU120 | HU160 | rpd3Δ_1 | rpd3Δ_2 | rpd3Δ_3 |
|---|---|---|---|---|---|---|---|---|---|---|---|---|---|---|---|
| Cortical Patches | 0 | 0 | 0 | 0 | 0 | 0 | 0 | 0 | 0 | 0 | 0 | 0 | 0 | 0 | 0 |
| Bud | 0 | 0 | 0 | 0 | 0 | 0 | 0 | 0 | 0 | 0 | 0 | 0 | 0 | 0 | 0 |
| Bud Neck | 3.6 | 0 | 0 | 0 | 0 | 0 | 0 | 0 | 0 | 0 | 0 | 0 | 0 | 0 | 0 |
| Bud Site | 0 | 0 | 0 | 0 | 0 | 0 | 0 | 0 | 0 | 0 | 0 | 0 | 0 | 0 | 0 |
| Cell Periphery | 0 | 0 | 0 | 0 | 0 | 0 | 0 | 0 | 0 | 0 | 0 | 0 | 0 | 0 | 0 |
| Cytoplasm | 0.6 | 3.6 | 3.3 | 4.1 | 5.3 | 3.6 | 4.3 | 3.4 | 3.6 | 1.4 | 2.2 | 4.1 | 1.0 | -0.6 | 0.4 |
| Endoplasmic Reticulum | 0 | 0 | 0 | 0 | 0 | 0 | 0 | 0 | 0 | 0 | 0 | 0 | 0 | 0 | 0 |
| Endosome | 0 | 2.7 | 0 | 0 | 0 | 0 | 0 | 0 | 0 | 0 | 3.1 | 5.7 | 2.5 | 0 | 0 |
| Golgi | 0 | 0 | 0 | 0 | 0 | 0 | 0 | 0 | 0 | 0 | 0 | 0 | 0 | 0 | 0 |
| Mitochondria | -1.0 | 0.3 | 0 | 0 | 0 | 0 | 0 | 0 | 0 | -1.4 | 0 | 0 | 0 | -0.8 | 1.8 |
| Nucleus | -10.9 | -8.3 | -11.9 | -13.3 | -13.4 | -13.8 | -12.9 | -13.6 | -13.7 | -7.4 | -9.7 | -11.0 | -6.6 | -5.4 | -8.3 |
| Nuclear Periphery | 0 | 0 | 0 | 0 | 0 | 0 | 0 | 0 | 0 | 0 | 0 | 0 | 0 | 0 | 0 |
| Nucleolus | 8.1 | 1.1 | 0 | 0 | 0 | 0 | 0 | 0 | 0 | 7.3 | 7.5 | 3.9 | 6.5 | 7.7 | 8.7 |
| Peroxisomes | 0 | 0 | 0 | 0 | 0 | 0 | 0 | 0 | 0 | 0 | 0 | 0 | 0 | 0 | 0 |
| SpindlePole | 9.4 | 4.3 | 0 | 0 | 0 | 0 | 0 | 0 | 0 | 5.8 | 7.7 | 6.8 | 1.0 | -2.3 | -1.6 |
| Vacuole | 0 | 1.3 | 0 | 0 | 0 | 0 | 0 | 0 | 0 | 0 | 0 | 0 | 1.6 | 0 | 2.0 |
External localization resources
Images






























Protein Concentration and Protein Localization Data
| R1 | R2 | R3 | ||||||||||||||||
|---|---|---|---|---|---|---|---|---|---|---|---|---|---|---|---|---|---|---|
| G1 Pre-START | G1 Post-START | S/G2 | Metaphase | Anaphase | Telophase | G1 Pre-START | G1 Post-START | S/G2 | Metaphase | Anaphase | Telophase | G1 Pre-START | G1 Post-START | S/G2 | Metaphase | Anaphase | Telophase | |
| Concentration | 0.4931 | 0.6998 | 0.5234 | 0.1875 | 0.0437 | 0.4062 | 0.4229 | 1.0461 | 0.9916 | 0.7874 | 0.767 | 0.992 | 1.0347 | 1.1208 | 0.6901 | 1.2231 | 1.352 | 0.7453 |
| Actin | 0.0142 | 0 | 0.0004 | 0 | 0 | 0.0125 | 0.0048 | 0.0051 | 0.0133 | 0.0013 | 0.0084 | 0.0036 | 0.0215 | 0 | 0.0087 | 0.0577 | 0.0058 | 0.0002 |
| Bud | 0.0005 | 0.0001 | 0.0002 | 0.0001 | 0.0001 | 0.0002 | 0.0004 | 0.0005 | 0.0001 | 0.0002 | 0.0001 | 0.0001 | 0.0004 | 0.0001 | 0.0002 | 0.0003 | 0.0002 | 0.0001 |
| Bud Neck | 0.0071 | 0.0017 | 0.002 | 0.0006 | 0.0034 | 0.0047 | 0.003 | 0.002 | 0.002 | 0.0059 | 0.002 | 0.0114 | 0.0021 | 0.0054 | 0.0029 | 0.0017 | 0.0015 | 0.0039 |
| Bud Periphery | 0.001 | 0.0002 | 0.0005 | 0.0002 | 0.0002 | 0.0004 | 0.0013 | 0.0003 | 0.0003 | 0.0007 | 0.0006 | 0.0004 | 0.001 | 0.0002 | 0.0004 | 0.0006 | 0.0005 | 0.0003 |
| Bud Site | 0.0084 | 0.0016 | 0.0026 | 0.0005 | 0.0012 | 0.0007 | 0.0034 | 0.0015 | 0.003 | 0.0008 | 0.0003 | 0.0007 | 0.0025 | 0.0014 | 0.0025 | 0.0013 | 0.0031 | 0.0006 |
| Cell Periphery | 0.0004 | 0.0004 | 0.0004 | 0.0001 | 0.0001 | 0.0002 | 0.001 | 0.0007 | 0.0003 | 0.0009 | 0.0001 | 0.0002 | 0.0004 | 0.0006 | 0.0003 | 0.0005 | 0.0002 | 0.0002 |
| Cytoplasm | 0.006 | 0.0005 | 0.0009 | 0.0001 | 0.0001 | 0.0122 | 0.0159 | 0.0022 | 0.0007 | 0.0015 | 0.0026 | 0.0003 | 0.0013 | 0.0022 | 0.0003 | 0.0002 | 0.0006 | 0.0001 |
| Cytoplasmic Foci | 0.0177 | 0.0065 | 0.0059 | 0.0002 | 0.001 | 0.0073 | 0.0066 | 0.0033 | 0.0031 | 0.0036 | 0.002 | 0.0072 | 0.0187 | 0.0078 | 0.0116 | 0.0069 | 0.0116 | 0.0024 |
| Eisosomes | 0.0005 | 0 | 0 | 0 | 0 | 0.0001 | 0.0002 | 0 | 0.0003 | 0.0001 | 0.0003 | 0.0001 | 0.0003 | 0 | 0.0001 | 0.0001 | 0.0001 | 0 |
| Endoplasmic Reticulum | 0.0029 | 0.0002 | 0.0005 | 0 | 0 | 0.0004 | 0.0021 | 0.0006 | 0.0005 | 0.0032 | 0.0044 | 0.0003 | 0.0015 | 0.0001 | 0.0004 | 0.0002 | 0.0009 | 0.0001 |
| Endosome | 0.0173 | 0.0041 | 0.0066 | 0.0001 | 0.0003 | 0.0055 | 0.0096 | 0.0046 | 0.002 | 0.0337 | 0.0181 | 0.0062 | 0.024 | 0.0019 | 0.0053 | 0.0083 | 0.0285 | 0.0016 |
| Golgi | 0.0044 | 0.0006 | 0.0017 | 0 | 0.0002 | 0.0025 | 0.0041 | 0.0008 | 0.0013 | 0.0117 | 0.0054 | 0.0033 | 0.011 | 0.0008 | 0.0029 | 0.0245 | 0.0148 | 0.0008 |
| Lipid Particles | 0.0212 | 0.018 | 0.0238 | 0.0011 | 0.0015 | 0.0278 | 0.0249 | 0.0193 | 0.0153 | 0.0606 | 0.0451 | 0.05 | 0.0627 | 0.0303 | 0.0227 | 0.0435 | 0.0677 | 0.0131 |
| Mitochondria | 0.0083 | 0.0002 | 0.0015 | 0.0003 | 0.0002 | 0.0029 | 0.0192 | 0.0006 | 0.0016 | 0.0576 | 0.0392 | 0.0011 | 0.0104 | 0.0003 | 0.0085 | 0.0089 | 0.0049 | 0.0021 |
| None | 0.0035 | 0.0003 | 0.0021 | 0.0001 | 0.0002 | 0.0032 | 0.0006 | 0.0018 | 0.0013 | 0.0054 | 0.0073 | 0.0005 | 0.0031 | 0.0128 | 0.0003 | 0.0003 | 0.0013 | 0.0002 |
| Nuclear Periphery | 0.0267 | 0.0062 | 0.0079 | 0.0003 | 0.0027 | 0.0078 | 0.0033 | 0.0066 | 0.0075 | 0.0241 | 0.0667 | 0.0131 | 0.015 | 0.0037 | 0.0028 | 0.0041 | 0.0515 | 0.0062 |
| Nucleolus | 0.5281 | 0.6829 | 0.7739 | 0.6054 | 0.6274 | 0.5824 | 0.721 | 0.7726 | 0.8183 | 0.5731 | 0.4115 | 0.6555 | 0.6373 | 0.7068 | 0.7759 | 0.647 | 0.542 | 0.7409 |
| Nucleus | 0.1673 | 0.2086 | 0.1028 | 0.3879 | 0.2395 | 0.1847 | 0.1103 | 0.1318 | 0.1028 | 0.1838 | 0.2401 | 0.1438 | 0.0952 | 0.1666 | 0.1183 | 0.1521 | 0.1646 | 0.1415 |
| Peroxisomes | 0.0092 | 0.0013 | 0.0018 | 0.0001 | 0.0002 | 0.0027 | 0.0067 | 0.0007 | 0.0028 | 0.0015 | 0.0032 | 0.0041 | 0.0121 | 0.0008 | 0.011 | 0.0026 | 0.0138 | 0.0011 |
| Punctate Nuclear | 0.1487 | 0.06 | 0.06 | 0.0023 | 0.1211 | 0.1376 | 0.0522 | 0.0316 | 0.0217 | 0.0132 | 0.1368 | 0.0964 | 0.0747 | 0.053 | 0.0231 | 0.0356 | 0.0829 | 0.0827 |
| Vacuole | 0.004 | 0.0061 | 0.0037 | 0.0003 | 0.0004 | 0.0024 | 0.0052 | 0.0112 | 0.0013 | 0.0118 | 0.0013 | 0.0012 | 0.003 | 0.0044 | 0.0015 | 0.0029 | 0.0019 | 0.0011 |
| Vacuole Periphery | 0.0024 | 0.0005 | 0.0007 | 0.0001 | 0.0001 | 0.0018 | 0.0041 | 0.002 | 0.0004 | 0.0053 | 0.0045 | 0.0006 | 0.0018 | 0.0007 | 0.0004 | 0.0008 | 0.0015 | 0.0007 |
Sequencing Data
| R1 | R2 | |||||||||
|---|---|---|---|---|---|---|---|---|---|---|
| G1 Post-START | S/G2 | Metaphase | Anaphase | Telophase | G1 Post-START | S/G2 | Metaphase | Anaphase | Telophase | |
| Gene Expression | 16.8666 | 5.8365 | 9.3838 | 11.6337 | 19.0466 | 9.7881 | 7.1308 | 7.6341 | 7.9699 | 12.0333 |
| Translational Efficiency | 1.2252 | 2.4897 | 1.4081 | 0.9169 | 0.7514 | 1.3378 | 1.6277 | 1.2917 | 0.9287 | 0.9425 |
Hit Data
| Dataset | Hit |
|---|---|
| Protein Concentration | ✘ |
| Protein Localization | ✔ |
| Gene Expression | ✔ |
| Translational Efficiency | ✔ |
Endocytosis
| Temp | Actin Patch (Sac6-tdTomato) | Cortical Patch (Sla1-GFP) | Late Endosome (Snf7-GFP) | Vacuole (Vph1-GFP) |
|---|---|---|---|---|
| 37℃ | ||||
| RT |
Cell Cycle Omics
CYCLoPs (Bmt2-GFP)
| Gene / Allele | Actin Patch (Sac6-tdTomato) | Cortical Patch (Sla1-GFP) | Late Endosome (Snf7-GFP) | Vacuole (Sac6-tdTomato) |
|---|
| Gene | Images |
|---|
| Gene | Images |
|---|
Images are not yet available
Images are not yet available